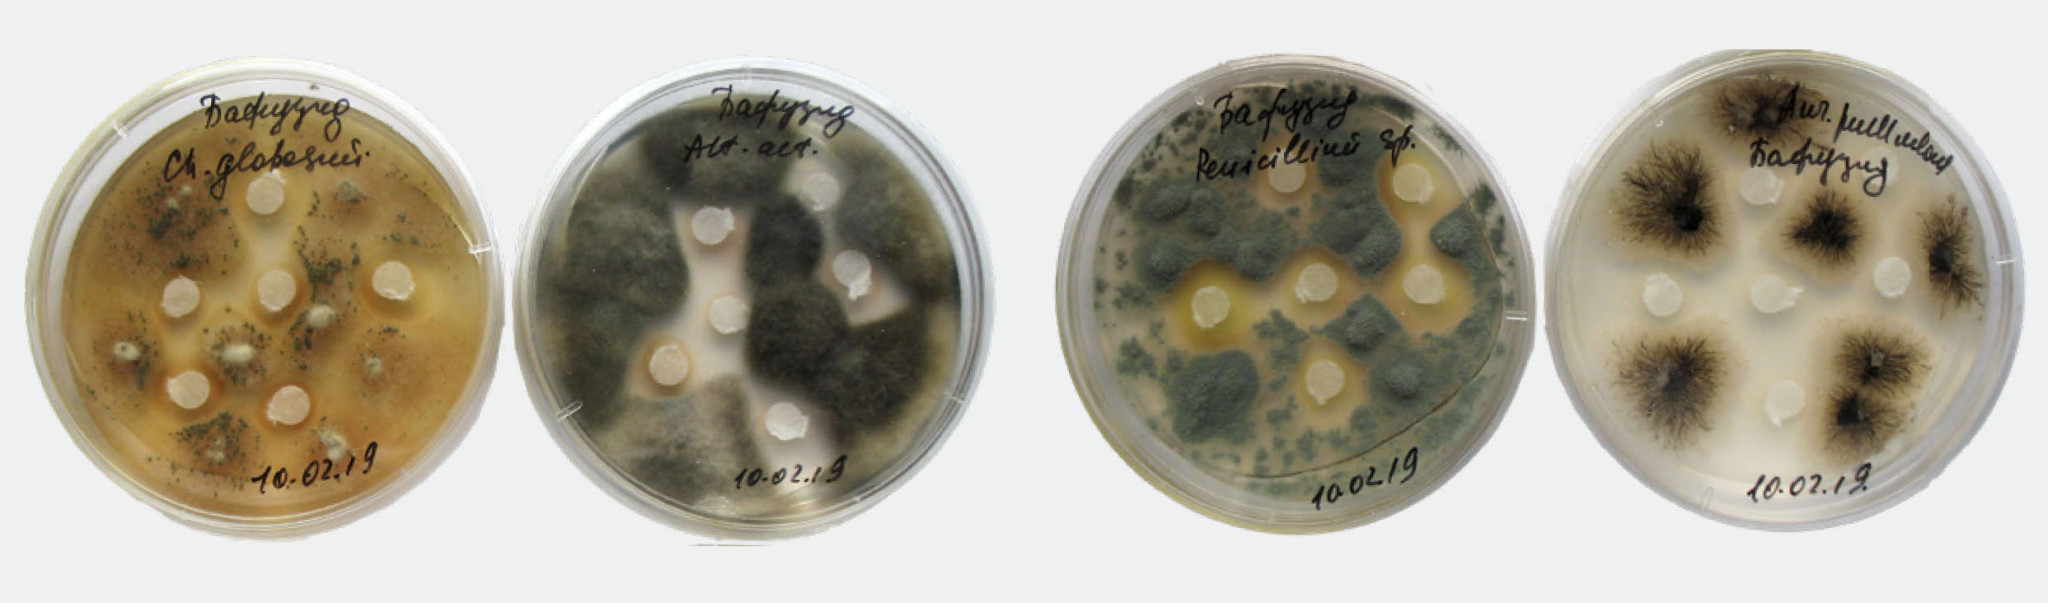

Санкт-Петербургский университетКультура
Он же памятник! Кто его разрушит?
Проблема биоповреждений памятников культурного наследия остро стоит во многих странах мира. Биологи СПбГУ уже более 20 лет ищут эффективные способы решения проблемы. В этой области они входят в число ведущих специалистов в мире.

Сохранение памятников культурного наследия является одной из приоритетных задач современного общества. Особенно актуальна эта проблема там, где памятники экспонируются на открытом воздухе и подвергаются разрушительному воздействию окружающей среды. Одним из факторов повреждения является развитие на них биологических объектов (бактерий, грибов, водорослей, лишайников, споровых и семенных растений), хорошо заметных даже невооруженным глазом. Позеленевшие или почерневшие мраморные скульптуры заметно теряют в эстетическом облике, а их поверхность постепенно разрушается.
Наблюдать
До настоящего времени не найдено эффективных способов решения проблемы. Ученые сходятся во мнении, что одним из важнейших этапов подобных исследований должен стать мониторинг состояния памятников. Это сложный и длительный процесс. Его эффективность во многом определяется регулярностью наблюдений, сочетанием полевых и лабораторных методов оценки происходящих изменений. Именно на основании результатов мониторинговых исследований должны разрабатываться рекомендации по защите объектов культурного наследия от биологических повреждений. Объектами таких систематических наблюдений со стороны биологов СПбГУ стали скульптурные памятники, расположенные в некрополях Государственного музея городской скульптуры Санкт-Петербурга. Это уникальный музей под открытым небом. В его ведении находятся выдающиеся по своей художественной и исторической ценности собрания петербургских памятников и произведений мемориального искусства ХVIII–ХХ веков.
С 1998 года в Некрополе ХVIII века и Некрополе мастеров искусств проводится мониторинг состояния памятников, созданных из различных типов природного камня. В этой работе принимают участие ученые, студенты и аспиранты СПбГУ, а также специалисты других учебных заведений, научных и музейных организаций города, объединенные идеей сохранения уникального собрания памятников нашего города. За этот период удалось установить природу биологических повреждений каменной скульптуры, оценить динамику и факторы обрастания памятников, а также определить основные подходы к сохранению объектов культурного наследия.

Идентифицировать
Биологи выявили сотни видов микроорганизмов, способных поселяться на объектах культурного наследия. С применением современных молекулярно-генетических и культуральных методов удалось установить, что чаще всего на памятниках поселяются темноокрашенные микроскопические грибы из отдела Ascomycota (аскомицеты), которые наиболее устойчивы к воздействию городской среды. На мраморных скульптурах нередко развиваются водоросли из отдела Chlorophyta (зеленые). В составе сообществ обрастаний часто отмечаются цианобактерии, а также накипные лишайники. Все эти организмы-деструкторы не только повреждают памятник, но и взаимодействуют друг с другом, что существенно усложняет борьбу с н ими. Их распределение на памятнике зависит от его микрорельефа, свойств каменного материала, а также окружающих условий.
Занимаясь этой проблемой, невольно ощущаешь себя в роли врача, который должен точно поставить «диагноз» памятнику и предложить рекомендации по защите от «недуга». Однако с ложность зачастую состоит в том, что причин ухудшения состояния памятников сразу несколько. Это и физико-химические факторы, и антропогенное влияние, и, конечно, биологические обрастания. В такой ситуации требуется комплексный (междисциплинарный) подход к решению проблемы. Неслучайно в Университете сложилось сообщество ученых, биологов и геологов, которые вместе изучают причины и последствия разрушительных процессов на памятниках в городской среде. Такие исследования привели к более глубокому пониманию процессов и механизмов деградации памятников. Оказалось, что наиболее подвержены биологической колонизации карбонатные породы (известняки и мраморы). Они могут быть существенно разрушены спустя 20–30 лет после экспонирования на открытом воздухе в городской среде. Зернистое, часто пористое строение карбонатной породы позволяет микроорганизмам проникать в структурные пространства поверхностного слоя камня на значительную глубину по трещинам, бороздам и углублениям, вызывая существенные повреждения камня.
Именно микроорганизмы считаются не только первопоселенцами на памятниках, но и одними из наиболее агрессивных деструкторов каменного материала. Так, например, они используют материал памятника или его отдельные компоненты, а также оседающие на поверхности атмосферные загрязнения в качестве источника получения энергии для роста и развития. Продукты метаболизма микроорганизмов обладают коррозионной активностью, что тоже оказывает пагубное воздействие. Но и это еще не все. За счет роста биопленок непосредственно в материале памятника происходит его механическое разрушение.
В научной литературе утвердился термин «биологическое (или биогенное) выветривание», под которым понимается заметное изменение свойств материала вследствие воздействия на него организмов в процессе их жизнедеятельности (возможно остаточное воздействие на материал продуктов метаболизма биологических объектов после их гибели). Поиск эффективных способов противодействия биологическому разрушению материалов памятников должен базироваться на знании состава поселенцев, понимании основных механизмов их воздействия на материал, а также условий, при которых происходит развитие деструктивных процессов.
Защищать
Основные способы защиты памятников на открытом воздухе от биологических повреждений можно разделить на механические, физические, химические и биологические. Все они направлены на удаление с поверхности различных видов наслоений биологической природы и предотвращение последующей биологической колонизации.
Сегодня наиболее широко применяется химический метод защиты материалов от биоразрушения, основанный главным образом на применении биоцидов — химических веществ, уничтожающих (подавляющих) микроорганизмы, поселяющиеся на конкретном материале. Несмотря на значительный прогресс в разработке биоцидов с различными действующими веществами, проблемы их эффективности, экологической безопасности и пролонгированного защитного действия остаются до сих пор нерешенными. В этом отношении исследования в музейных некрополях, направленные на предотвращение биологических повреждений скульптурных памятников, которые проводятся уже два десятка лет, имеют большое значение для определения наиболее эффективных защитных составов и технологий их применения.
Исследования в области создания, испытания и оценки эффективности биоцидных составов ориентированы на понимание механизмов действия биоцидов на организмы-деструкторы. К таким механизмам можно отнести физико-химические взаимодействия с определенными структурами микробной клетки; специфические взаимодействия с биологическими макромолекулами; нарушение биоцидами процессов метаболизма и круговорота энергии в клетках микроорганизмов. При этом необходимо у читывать способность микроорганизмов к выработке устойчивости (резистентности) к действию защитных составов. Кроме того, сложность состоит еще и в том, что микроорганизмы повреждают памятники не в одиночку, а чаще всего формируют так называемые биопленки. Они обычно имеют сложный состав и способны включать десятки и даже сотни видов микроорганизмов, что требует такого подбора биоцидов, которые эффективно предотвращают рост повреждающего сообщества, в особенности доминирующих видов.
Найти управу в лаборатории
Исследования в данном направлении представляют собой весьма длительный процесс. Всё начинается в лаборатории. Здесь ведется работа со штаммами биодеструкторов, которые выделены с поврежденных памятников. Обычно это микроскопические грибы, известные своей способностью повреждать самые разнообразные материалы. Например, это темноокрашенные грибы из родов Cladosporium (кладоспориум) и Aureobasidium (ауреобазидиум), которые доминируют на петербургских памятниках. Испытания биоцидных составов проводятся с культурами грибов в моделируемых условиях.
Это позволяет выбрать наиболее перспективные варианты защитных композиций для последующих испытаний уже на самих памятниках. На втором этапе выбираются пробные площадки, где анализируется состав микробных сообществ, после чего проводится обработка экспериментальным биоцидом.
Важно, чтобы защитный состав не только подавлял развитие микроорганизмов, но и не оказывал отрицательного воздействия на материал памятника. Только на основании полученных в ходе таких испытаний данных биоцид рекомендуется к применению на конкретных объектах культурного наследия. Эффективность его применения может быть оценена по совокупности показателей, в том числе по изменению спектральных характеристик обработанной поверхности. На многих памятниках музейных некрополей специалистами Музея городской скульптуры во взаимодействии с биологами СПбГУ были применены биоцидные составы (в ходе проведения работ по консервации), что позволило повысить эффективность защиты памятников от биологических повреждений.
Но это еще далеко не всё. Как долго состав будет защищать памятник от биообрастания? Это один из самых болезненных вопросов, когда речь заходит об эффективности биоцидов. Уникальность исследований, проведенных специалистами СПбГУ, состоит в том, что эффективность применяемых защитных составов оценивалась на протяжении ряда лет, что позволило охарактеризовать скорость восстановления микробных сообществ на памятниках в условиях мегаполиса. Оказалось, что для многих памятников музейных некрополей срок восстановления микробных сообществ (по видовому составу и численности микроорганизмов) колеблется от четырех до семи лет в зависимости от состояния памятника, а также условий его экспонирования. Это может означать необходимость проведения повторных мероприятий для защиты памятника. Важно отметить, что параллельно с работами по защите памятников некрополей постоянно проводятся исследования и поиск новых, еще более эффективных и экологически безопасных составов, которые в будущем помогут сохранить уникальные памятники Санкт-Петербурга.

Что почитать
Результаты исследований биологов СПбГУ, проведенных в некрополях Государственного музея городской скульптуры Санкт-Петербурга, обобщены в двух монографиях:
- Памятники музейных некрополей Санкт-Петербурга: бытование, материалы, диагностика сохранности. Под ред. Власова Д. Ю., Франк-Каменецкой О. В., Рытиковой В. В. СПб.: 2016. 171 С.
- The Effect of the Environment on Saint Petersburg’s Cultural Heritage. Results of Monitoring the Historical Necropolis Monuments. EDS: Frank-Kamenetskaya O. V., Vlasov D. YU., Rytikova V. V. 2019, Springer. 188 p.
О том, как микроорганизмы формируют биопленки на поверхностях памятников, можно прочесть в статье:
- Сазанова К. В., Зеленская М. С., Бобир С. Ю., Власов Д. Ю. Микромицеты в биопленках на каменных памятниках Санкт-Петербурга // Микология и фитопатология. 2020. Т. 54 (5). С. 329–339.
Дмитрий Юрьевич Власов, профессор СПбГУ (кафедра ботаники)
Предоставлено Д. Ю. Власовым
Марина Станиславовна Зеленская, старший научный сотрудник СПбГУ (кафедра ботаники)
Предоставлено М. С. Зеленской
Хочешь стать одним из более 100 000 пользователей, кто регулярно использует kiozk для получения новых знаний?
Не упусти главного с нашим telegram-каналом: https://kiozk.ru/s/voyrl